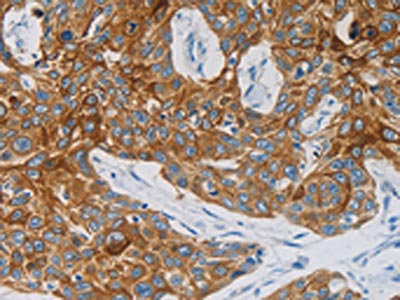

NDRG4 Antibody
-
中文名稱:NDRG4兔多克隆抗體
-
貨號(hào):CSB-PA238244
-
規(guī)格:¥1100
-
圖片:
-
The image on the left is immunohistochemistry of paraffin-embedded Human esophagus cancer tissue using CSB-PA238244(NDRG4 Antibody) at dilution 1/60, on the right is treated with synthetic peptide. (Original magnification: ×200)
-
Gel: 10%SDS-PAGE, Lysate: 30 μg, Lane: Mouse heart tissue, Primary antibody: CSB-PA238244(NDRG4 Antibody) at dilution 1/1200, Secondary antibody: Goat anti rabbit IgG at 1/8000 dilution, Exposure time: 10 seconds
-
-
其他:
產(chǎn)品詳情
-
Uniprot No.:
-
基因名:NDRG4
-
別名:BDM1 antibody; Brain development-related molecule 1 antibody; KIAA1180 antibody; Ndrg4 antibody; NDRG4_HUMAN antibody; Protein NDRG4 antibody; SMAP 8 antibody; SMAP-8 antibody; Vascular smooth muscle cell-associated protein 8 antibody
-
宿主:Rabbit
-
反應(yīng)種屬:Human,Mouse,Rat
-
免疫原:Synthetic peptide of Human NDRG4
-
免疫原種屬:Homo sapiens (Human)
-
標(biāo)記方式:Non-conjugated
-
抗體亞型:IgG
-
純化方式:Antigen affinity purification
-
濃度:It differs from different batches. Please contact us to confirm it.
-
保存緩沖液:-20°C, pH7.4 PBS, 0.05% NaN3, 40% Glycerol
-
產(chǎn)品提供形式:Liquid
-
應(yīng)用范圍:ELISA,WB,IHC
-
推薦稀釋比:
Application Recommended Dilution ELISA 1:2000-1:10000 WB 1:1000-1:5000 IHC 1:50-1:200 -
Protocols:
-
儲(chǔ)存條件:Upon receipt, store at -20°C or -80°C. Avoid repeated freeze.
-
貨期:Basically, we can dispatch the products out in 1-3 working days after receiving your orders. Delivery time maybe differs from different purchasing way or location, please kindly consult your local distributors for specific delivery time.
-
用途:For Research Use Only. Not for use in diagnostic or therapeutic procedures.
相關(guān)產(chǎn)品
靶點(diǎn)詳情
-
功能:Contributes to the maintenance of intracerebral BDNF levels within the normal range, which is necessary for the preservation of spatial learning and the resistance to neuronal cell death caused by ischemic stress. May enhance growth factor-induced ERK1 and ERK2 phosphorylation, including that induced by PDGF and FGF. May attenuate NGF-promoted ELK1 phosphorylation in a microtubule-dependent manner.
-
基因功能參考文獻(xiàn):
- NDRG4 is exclusively expressed by central, peripheral and enteric neurons/nerves, suggesting a neuronal-specific role of this protein PMID: 28524415
- NDRG4 promoter hypermethylation contributed to the risk of gastric cancer and predicted a poor prognosis in Chinese gastric cancer patients. PMID: 28042954
- NDRG4 might play an important role during early pregnancy. PMID: 27175791
- NDRG4 - the biomarker of a currently in-use multi-target stool DNA test was commonly expressed in tumor tissue specimens, independent of Fecal Immunochemical Test result. PMID: 28044229
- Data indicate that patients with tumor of reduced NDRG family member 4 protein (NDRG4) mRNA level had unfavorable disease-free and overall survival. PMID: 26515606
- Study shows that NDRG4 was significantly up-regulated in glioblastomas (GBM) and seems to play a role in GBM prognosis. These results indicate that NDRG4 gene in MGMT-methylated cells is a putative tumor-suppressor gene and an oncogene in cells with unmethylated MGMT. PMID: 26976975
- These findings bring novel insight to the roles of NDRG4 in meningioma progression PMID: 26053091
- A homozygous variant in NDRG4 may be the causative variant of the autosomal recessive form of infantile myofibromatosis. PMID: 25241110
- Methylation level in stool decreases dramatically following colorectal cancer resection PMID: 24993691
- summarizes the current research on NDRG3 and NDRG4,including the molecular structure, cellular and tissue distribution, biological function, and function in cancer. PMID: 23725756
- expression of NDRG4 is downregulated in human gliomas. The glioma patients with lower NDRG4 expression have a poor prognosis. PMID: 22399192
- NDRG4 is involved in modulating cell proliferation, invasion, migration and angiogenesis in meningioma, and may play a valuable role as a molecular target in its treatment PMID: 22869042
- Over expression of NDRG4 inhibited proliferation of GBM cells. PMID: 22489821
- Cloning and expression of the gene; specifically expressed in brain and heart PMID: 11936845
- smap8 is involved in the regulation of mitogenic signalling in vascular smooth muscle cells, possibly in response to a homocysteine-induced injury [SMAP8] PMID: 12755708
- NDRG4 is a candidate tumor suppressor gene in colorectal cancer whose expression is frequently inactivated by promoter methylation. PMID: 19535783
- NDRG4 is required for cell cycle progression and survival, thereby diverging in function from its tumor suppressive family member NDRG2 in astrocytes and GBM cells PMID: 19592488
- NDRG4 overexpression enhances ERK activation PMID: 16408304
顯示更多
收起更多
-
亞細(xì)胞定位:Cytoplasm, cytosol.
-
蛋白家族:NDRG family
-
組織特異性:Expressed predominantly in brain and heart (at protein level). In the brain, detected in astrocytes. Isoform 1 and isoform 2 are only expressed in brain. Isoform 3 is expressed in both heart and brain. Up-regulated in glioblastoma multiforme cells.
-
數(shù)據(jù)庫鏈接:
Most popular with customers
-
-
Phospho-YAP1 (S127) Recombinant Monoclonal Antibody
Applications: ELISA, WB, IHC
Species Reactivity: Human
-
-
-
-
-
-